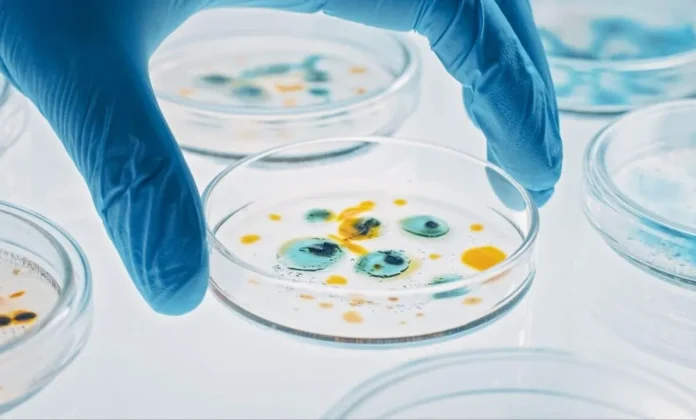
Zbulohet një mikrob i ri në stacionin kinez hapësinor me aftësi të jashtëzakonshme për mbijetesë

Në një zbulim që po përshkruhet si “pikë kthese” për shkencën, studiuesit në Australi kanë identifikuar gjurmë të fosilizuara kthetrash që mund të jenë më të vjetrat në botë nga amniotët – grupi i kafshëve nga të cilat më vonë u zhvilluan gjitarët, reptilët dhe zogjtë. Ky zbulim i shtyn fillimet e tyre me rreth 40 milionë vjet më herët sesa besohej deri më tani.
Fosilet u gjetën në brigjet e lumit Broken në jug të Australisë, pranë qytetit Mansfield, dhe janë të vendosura në shtresa guri rëre që datojnë 354–358 milionë vjet më parë. Ato përfshijnë gjurmë me pesë gishta dhe madje edhe shenja thonjsh dhe gërvishtjesh, të ngjashme me ato të reptilëve të hershëm.
Sipas profesor John Long, paleontolog nga Universiteti i Flinders dhe autori kryesor i studimit të publikuar në revistën Nature, ky zbulim “rishkruan historinë e evolucionit të amniotëve”.
Australia, jo Evropa?
Për dekada me radhë, studiuesit besonin se amniotët u shfaqën për herë të parë në hemisferën veriore, në rajone si Evropa dhe Amerika e Veriut. Por këto gjurmë të reja – shumë më të vjetra se çdo fosil i mëparshëm i amniotëve – tregojnë se ndoshta origjina e tyre ishte në Gondwana, kontinenti i lashtë që përfshinte Australinë.
Zbulimi u bë nga Craig Eury dhe John Eason, eksplorues vendas që i dërguan një foto të fosileve profesorit Long me pyetjen: “A ka vlerë kjo?”. Reagimi i tij ishte i menjëhershëm: “Isha pa fjalë,” tha ai.
Sipas analizës, një shi i lashtë kishte lënë vraga të lehta mbi gurin, duke dëshmuar se sipërfaqja kishte qenë dikur e ekspozuar. Më pas, një ose më shumë amniotë ecnin mbi të, duke lënë pas gjurmë të qarta këmbësh dhe thonjsh. Këto janë gjurmët më të hershme të njohura deri më tani për këtë grup kafshësh të zhvilluara për jetën në tokë.
Ekipi australian bashkëpunoi me ekspertë të tjerë ndërkombëtarë, përfshirë studiues nga Universiteti i Uppsala në Suedi, për të konfirmuar moshën dhe rëndësinë e gjurmëve.
Një epokë kur Toka po ndryshonte
Gjurmët datojnë nga periudha karbonifer e hershme, një fazë kur Toka përjetonte ndryshime drastike. Niveli i oksigjenit ishte i lartë, pyjet gjigante mbulonin tokën, dhe lumenjtë përshkoheshin nga zvarranikë dhe peshq të mëdhenj. Ishte kjo periudhë kur, për herë të parë, disa kafshë filluan të riprodhohen jashtë ujit, një hap vendimtar në evolucionin e jetës në tokë.
Ndërsa gjurmët janë një dëshmi e fuqishme, studiuesit tani shpresojnë të gjejnë edhe fosile skeletore për të vërtetuar përfundimisht praninë e amniotëve në atë kohë. Dr. Erich Fitzgerald, paleontolog nga Instituti i Kërkimeve të Muzeut Victoria, e quajti këtë zbulim “provokues” dhe me “implikime të gjera për të kuptuar evolucionin tonë”.
Fitzgerald theksoi rëndësinë e bashkëpunimit midis ekspertëve dhe qytetarëve të pasionuar pas paleontologjisë, duke e përshkruar këtë rast si “një shembull të mrekullueshëm të asaj që mund të arrijmë kur eksplorojmë me kureshtje”.
Ky zbulim nuk është thjesht një rritje në numrin e fosileve të gjetura — ai ndryshon vetë kohën dhe vendin e origjinës së një grupi të tërë kafshësh që përfshin edhe njerëzit. Ai na kujton se e kaluara e Tokës është ende e mbushur me mistere, dhe se edhe një gjurmë e thjeshtë mund të na udhëheqë drejt njohjeve që sfidojnë të gjithë dijeninë tonë. /Inteligjenca n’3D